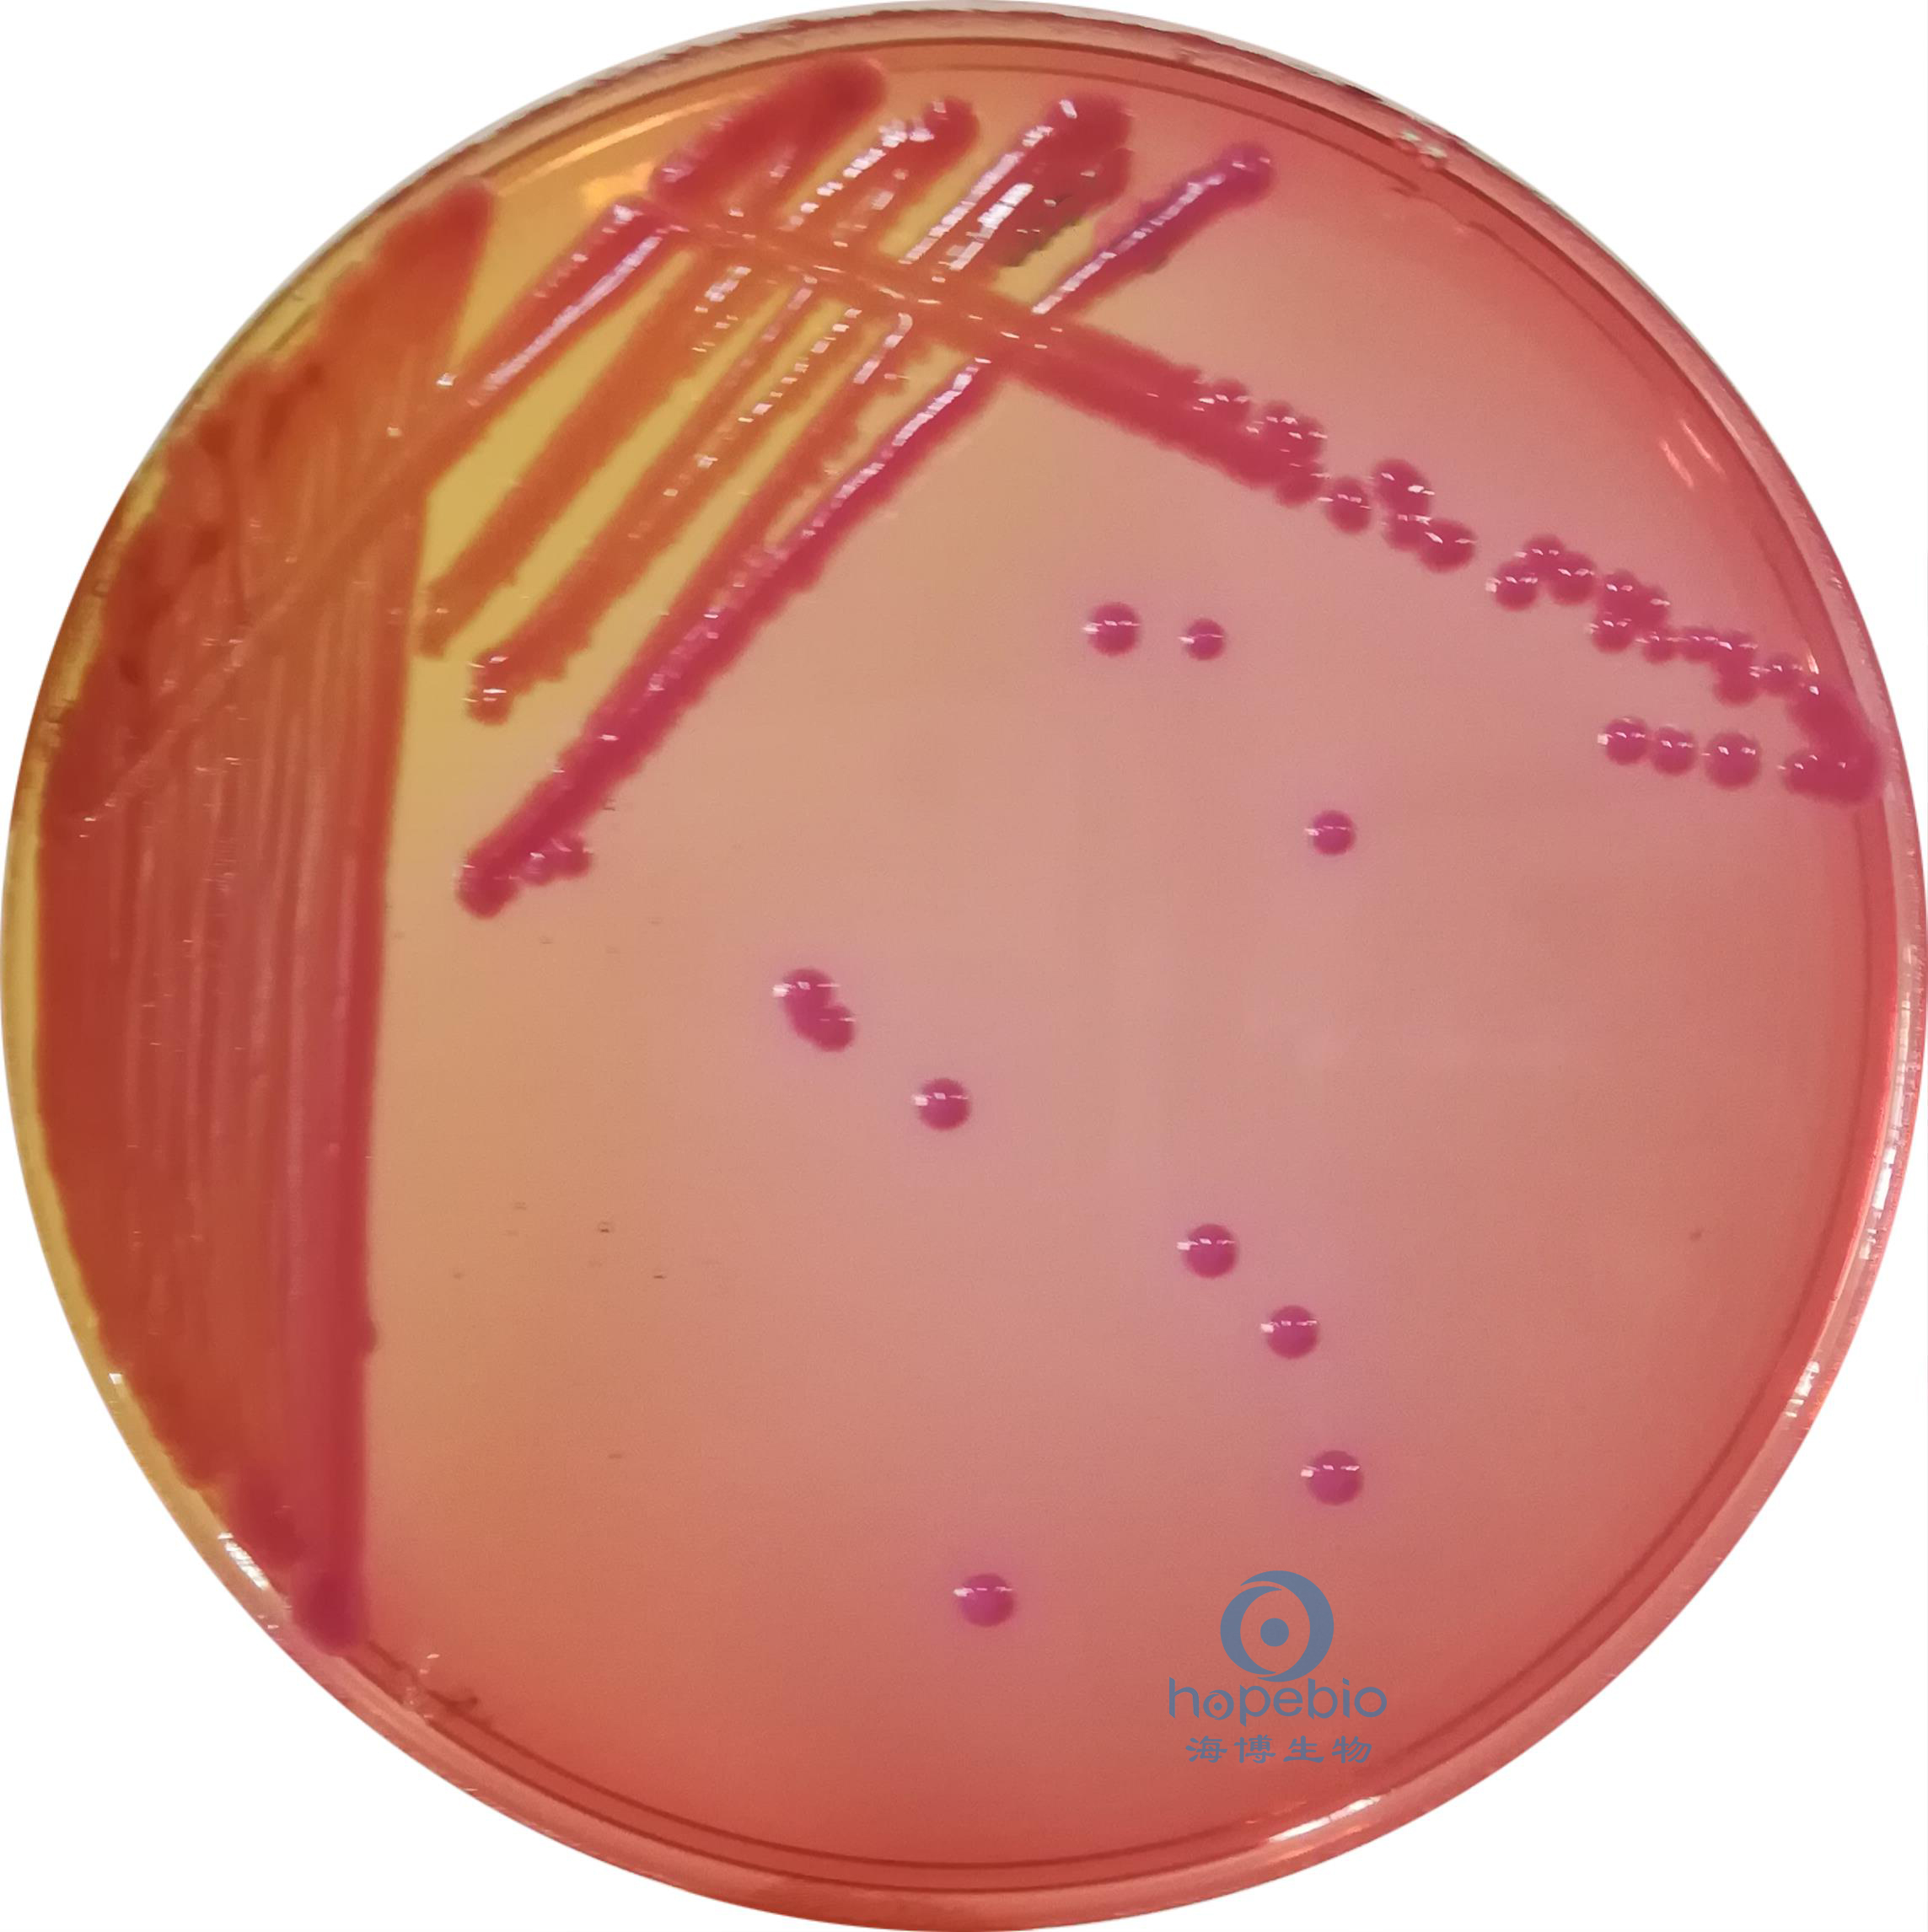

海博微信公众号
海博微信公众号
 海博天猫旗舰店
海博天猫旗舰店


 海博微信公众号
海博微信公众号
 海博天猫旗舰店
海博天猫旗舰店




一、参考标准
《SN/T 2206.3-2009 中华人民共和国出入境检验检疫行业标准 化妆品微生物检验方法 第3部分:肺炎克雷伯氏菌》。
二、生物学特征
革兰氏阴性杆菌,为较短粗的杆菌,大小0.5~0.8×1~2 um,单独、成双或短链状排列。无芽胞,无鞭毛,有较厚的荚膜,多数有菌毛。营养要求不高,在普通琼脂培养基上形成较大的灰白色粘液菌落,以接种环挑之,易拉成丝,有助鉴别。在肠道杆菌选择性培养基上能发酵乳糖,呈现有色菌落。
三、检验程序

图1 肺炎克雷伯氏菌检验程序
四、检验方法及结果
1、增菌
肺炎克雷伯氏菌在SCDLP液体培养基中36±1℃培养18-24h后生长浑浊。如图2所示。

a:空白对照 b:肺炎克雷伯氏菌CMCC(B)46117
图2 SCDLP液体培养基培养结果
2、选择性分离
自SCDLP培养液中,取1-2接种环,划线接种于胆硫乳琼脂平板(DHL)上,置36±1℃ 培养18-24 h。
在DHL平板上肺炎克雷伯氏菌菌落呈淡粉红色,大而隆起,光滑湿润,粘液状,相邻菌落容易融合成脓汁样,接种针挑取菌落时呈丝状粘连。如图3所示。
图3 肺炎克雷伯氏菌CMCC(B)46117在DHL平板上的培养结果
五、初步生化鉴定
从DHL平板上至少挑取5个典型或可疑菌落,如果平板上可疑菌落少于5个,则全部挑取,把挑取的可疑菌落分别穿刺于动力半固体琼脂,并接种到营养琼脂斜面培养基,36±1℃培养18-24 h。将营养琼脂斜面培养基上的纯培养物做革兰氏染色、氧化酶试验。
1、动力半固体琼脂
肺炎克雷伯氏菌在动力半固体培养基中无动力,延穿刺线生长。如图4所示,相比较大肠埃希氏菌在动力半固体培养基中有动力,呈扩散生长,培养基会出现浑浊现象。

a:大肠埃希氏菌ATCC 25922 b:肺炎克雷伯氏菌CMCC(B)46117
图4 动力半固体培养基培养结果
2、革兰氏染色
肺炎克雷伯氏菌染色结果为红色,为革兰氏阴性菌。

图5
3、氧化酶试验
肺炎克雷伯氏菌氧化酶试验不变色,为阴性。如图6所示,相比较铜绿假单胞菌变蓝为阳性。

a:铜绿假单胞菌ATCC 9027 b:肺炎克雷伯氏菌CMCC(B)46117
图6 氧化酶试验结果
六、后续生化鉴定
挑取无动力,革兰氏染色阴性,氧化酶试验阴性的菌进行后续生化鉴定。
1、尿素酶试验
划线接种于尿素酶生化管培养基中,培养基变为粉红色,为阳性。相比较鼠伤寒沙门氏菌不变色,为阴性。

a:空白对照 b:肺炎克雷伯氏菌CMCC(B)46117 c:鼠伤寒沙门氏菌ATCC14028
图7 尿素酶鉴定试验结果
2、靛基质生化鉴定试验
将菌接种于胰蛋白水培养基中,36±1℃培养24±2h。培养结束后,滴加Kovacs氏靛基质试剂2-4滴,立即观察现象。肺炎克雷伯氏菌为黄色环,为阴性。相比较大肠埃希氏菌为玫红色环,为阳性。

a:空白对照 b:肺炎克雷伯氏菌CMCC(B)46117 c:大肠埃希氏菌ATCC25922
图8 靛基质鉴定试验结果
3、MR鉴定试验
用MR-VP培养基培养结束后,滴加甲基红试剂,立即观察现象,肺炎克雷伯氏菌显黄色,为阴性。相比较大肠埃希氏菌显红色,为阳性。

a:空白对照 b:肺炎克雷伯氏菌CMCC(B)46117 c:大肠埃希氏菌ATCC25922
图9 MR鉴定试验结果
4、V-P鉴定试验
用MR-VP培养基培养结束后,滴加V-P试剂,继续培养0.5-4 h,观察现象。肺炎克雷伯氏菌变红,为阳性。相比较大肠埃希氏菌为黄色,为阴性。

a:空白对照 b:肺炎克雷伯氏菌CMCC(B)46117 c:大肠埃希氏菌ATCC25922
图10 V-P鉴定试验结果
5、西蒙氏枸橼酸盐利用试验
划线接种于西蒙氏枸橼酸盐培养基上,培养基变蓝,为阳性。

a:空白对照 b:肺炎克雷伯氏菌CMCC(B)46117
图11 西蒙氏枸橼酸盐培养基培养结果
6、赖氨酸脱羧酶鉴定试验
接种于赖氨酸脱羧酶肉汤生化管中,用无菌液体石蜡覆盖培养基液面,培养18-24 h。观察现象,肺炎克雷伯氏菌培养基呈紫色,为阳性。相比较,福氏志贺氏菌培养基呈黄色,为阴性。

a:空白对照 b:肺炎克雷伯氏菌CMCC(B)46117 c:福氏志贺氏菌ATCC12022
图12 赖氨酸脱羧酶鉴定试验结果
注:肺炎克雷伯氏菌生化特性见下表。

注:本文属海博生物原创,未经允许不得转载。
上一篇:食品中志贺氏菌检验简单介绍(上)
下一篇:单核增生李斯特氏菌的计数方法



